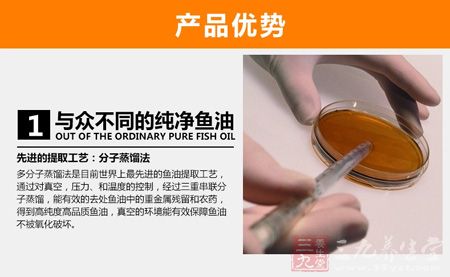
天狮牌鱼油磷脂软胶囊优势

天狮牌鱼油磷脂软胶囊
多分子蒸馏法是目前世界上先进的鱼油提取工艺,通过对真空,压力,和温度的控制,经过三重串联分钟蒸馏,能有效的去除鱼油中的重金属残留和农药,得到高纯度高品质鱼油,真空的环境能有效保障鱼油不被氧化破坏。
2、与众不同的优质鱼油
浓缩分溜的过程需要9个分馏塔,1号塔有效成分少,但质量品质好,9号塔浓缩鱼油含量好,但是过度氧化品质差,这两种都不能食用但是很多无良商家依然选用这种原料制成的鱼油品销售(中国市场很常见)。
优质金枪鱼、毛鱼油
离心分离、分馏层、30%鱼油

3、全球无污染深海萃取
精选全球纯净的6大深海鱼类,海峡狭长,海域辽阔,远离喧嚣,不是多得的人家净土,没有工业及汽车航船的污染,使这里的鱼类营养丰富,纯净无污染。
波利尼亚群岛、贝尔法斯特群岛
格林兰北部海域、挪威冰岛海域、法国布雷阿小岛

适用人群
为儿女操尽心的大脑

还没好好看看儿女眼就花了
